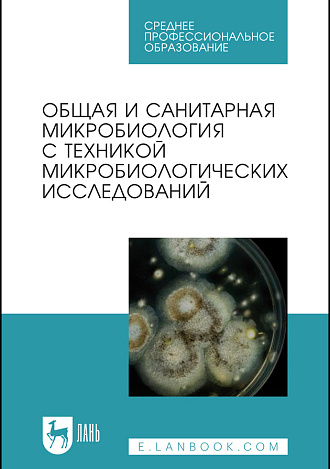
Общая и санитарная микробиология с техникой микробиологических исследований, Лабинская А. С., Блинкова Л. П., Ещина А. С., Булава Г.В., Вертиев Ю.В., Винокуров А.Е., Горобец О. Б., Дарбеева О.С., Жиленков Е.Л., Зверьков Д.А., Иванова С. М., Ильина Т.С., Корн М.Я., Кривопалова Н.С., Лукин И.Н., Мельникова В.А., Нехорошева А.Г., Романова Ю.М., Сидоренко С.В., Скаженик В.Ю., Скала Л.З., Трухина Г.М., Издательство Лань.

Общая и санитарная микробиология с техникой микробиологических исследований
Авторы:
Лабинская А. С., Блинкова Л. П., Ещина А. С., Булава Г.В., Вертиев Ю.В., Винокуров А.Е., Горобец О. Б., Дарбеева О.С., Жиленков Е.Л., Зверьков Д.А., Иванова С. М., Ильина Т.С., Корн М.Я., Кривопалова Н.С., Лукин И.Н., Мельникова В.А., Нехорошева А.Г., Романова Ю.М., Сидоренко С.В., Скаженик В.Ю., Скала Л.З., Трухина Г.М.
Уровень образования:
СПО
Дисциплины:
Теория и практика лабораторных микробиологических и иммунологических исследований, Микробиология, вирусология, иммунология, Микробиология, Иммунология, Основы микробиологии и иммунологии, Основы микробиологии и инфекционная безопасность, Проведение микробиологического и химико-бактериологического анализа, Выполнение микробиологических лабораторных исследований первой и второй категории сложности
Вид издания
учебное пособие для СПО
Год
2026
Объем
588 с.
ISBN
978-5-507-54555-1
Переплет
Твердый
Формат
13*20 см
Издание
7-е изд., стер.
В пособии освещены вопросы общей и санитарной микробиологии. Описаны требования по технике безопасности, методы дезинфекции и стерилизации, манипуляции с экспериментальными животными. Дана информация об оснащении бактериологической лаборатории и методах микробиологии, технике выращивания и изучения микроорганизмов в живом и окрашенном состоянии, приготовлении питательных сред, изучении антибиотикоустойчивости, дифференциально-диагностическом тестировании. Включен материал по бактериофагам, генетике бактерий, идентификации микроорганизмов с помощью ПЦР, об иммунитете и методах его оценки. Особое место занимают главы о физиолого-биохимических свойствах микроорганизмов и современных технологиях, применяемых в клинической микробиологии. Рассмотрены основные задачи и методы санитарно-микробиологических исследований воды, почвы, воздуха, пищевых продуктов, перевязочных средств и т. д.
Соответствует современным требованиям Федерального государственного образовательного стандарта среднего профессионального образования и профессиональным квалификационным требованиям.
Закрыть
Сообщить о поступлении
Укажите ваш e-mail, и мы пришлем уведомление, как только книга
станет доступна для покупки.